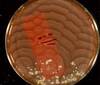

Enterobacteriaceae II 9/3/15 Flashcards
(21 cards)
What diseases are associated with Shigella?
-Bacillary Dysentery:
–Abdominal cramps
–Tenesmus
–Pus and blood in stool
–Fecal leukocytes
What diseases are associated with Edwardsiella?
-Gastroenteritis:
–Acute, self-limiting
–Watery diarrhea
–Typhoid-like illness:
—Bloody diarrhea
—Fever
—Nausea, vomiting
—Colonic ulcerations
—Terminal ileum nodularity
- Rarely septicemia
- Has been mistaken for salmonellosis and IBD (Crohn’s)
What bacterial strain is associated with the following disease state: -Nosocomial infections of the urinary and respiratory tracts -Endocarditis -Hospital acquired bacteremias -Rarely diarrhea -Rarely neonatal meningitis/brain abscess
Citrobacter
What strain of bacteria is associated with the following disease states:
- Asymptomatic carrier state
- Febrile gastroenteritis: malaise, nausea, vomiting, ab pain, diarrhea, self-limited (3-5d)
- Enteric fever/typhoid fever: increasing fever (2wks), GI symptoms (2wks)
- Septicemia: w/o GI involvement, immune-compromised pts
- Focal infections: disseminates from blood, osteomyelitis, endocarditis, meningitis, brain abscess
Salmonella
Describe the pathogenesis of gastroenteritis in Salmonella.
- Adhesin: Forms ruffle
- Pinocytosis via ruffle
- Invade large/small bowel/lamina propria
- Inflammatory response
What is the pathogenesis of Enteric Fever in Salmonella infection?
- Bind M cells
- Kills cell
- Go to Peyer’s patches
- Invade MACs
- Survive/Multiply intracellularly
- Spread to Bloodstream
- LPS = septic shock
Describe clinical manifestations of Salmonella Enteric Fever.
- Fever
- Headache
- Rose spots, pink macules/purpuric lesions
- Constipation
- Neuropsychiatric manifestations
Other complications: GI bleeds, Perforation of ileal ulcers, circulatory collapse
Describe clinical manifestations of Salmonella Bacteremia.
- Increased risk in:
- Pediatric
- Geriatric
- AIDS patients
- Similar to other gram negative bacteremias
- 10% localized supperative infections:
- Osteomyelitis, endocarditis, arthritis
- Rx: Third generation cephalosporins
What are the 3 major genera of the Klebsielleae tribe of Enterobacteriaceae?
Genus Klebsiella
Genus Enterobacter
Genus Serratia
What are the 4 important species of the Genus Klebsiella, and their clinical syndromes?
- K. pneumoniae and 2. K. oxytoca: Primary lobar pneumonia, necrosis, hemorrhage (“currant jelly” sputum”), bronchitis, (rarely UTIs and bacteremia in hospitals)
- K. ozaenae: Atrophic rhinitis (ozena), destruction of mucosa and fetid mucopurulent discharge
- K. rhinoscleromatis: Rhinoscleroma = chronic granulomatous disease involving mucosa of upper respiratory tract
What are the 2 important species of the genus Enterobacter, and what are their clinical syndromes?
- E. aerogenes
- E. cloacae
Clinical for both: colonize hospital patients:
- Cause opportunistic infections:
- Urinary tract
- Respiratory tract
- Cutaneous wounds
- Rarely Septicemia and meningitis
**Frequently resistant to antibiotics
Describe Serratia marcescens colonies.
-MacConkey: red colonies themselves (not from lactose fermentation)
What bacterial strain causes the following clinical syndromes:
- Nosocomial infections
- pneumoniae
- septicemia
- UTI
- surgical wounds
- cutaneous infections
**Cause of endocarditis/osteomyelitis in IV drug addicts
Serratia (i.e. S marcescens)
List the 2 important species of the Genus Proteus, and their respective indole status.
- P. mirabilis (-)
- P. vulgaris (+)
What bacterial genus has a “swarming” pattern of growth on blood agar?
Proteus
- also Lactose NEGATIVE on MacConkey
- also STRONGLY UREASE POSITIVE
Describe the clinical syndromes of Proteus mirabilis.
- Most frequently isolated species of Proteus
- Cause of UTI and wound infections
***Highly alkaline urea (strongly urease positive) = renal calculi
What clinical syndromes are associated with P. vulgaris?
-Most commonly recovered from infected sites in IC pts
What is the major species of the Genus Yersinia, and what are its key identifying features?
Yersinia enterocolitica
- Pinpoint colonies in MacConkey at 24 hr (grow fairly well)
- Incubated at 25 degrees Celsius (cooler Temp)
What is the predominant serotype of Yersinia enterocolitica that infects humans?
O:3
What is the epidemiology of Y. enterocolitica in humans?
- Pigs are major reservoir
- Diarrheal illness associated with Chitlin preparation
- Portal of entry is oral digestive route
- Almost always seen in young children
Describe Y. enterocolitica clinical syndromes and mechanism of pathogenesis.
- Organisms adhere to and penetrate ileum
- Terminal ileitis
- Lymphadenitis
- Acute enterocolitis
- Mimics appendicitis
- Diarrhea, fever, ab pain (1-2 weeks)
- Can also be associated with transfusion contamination